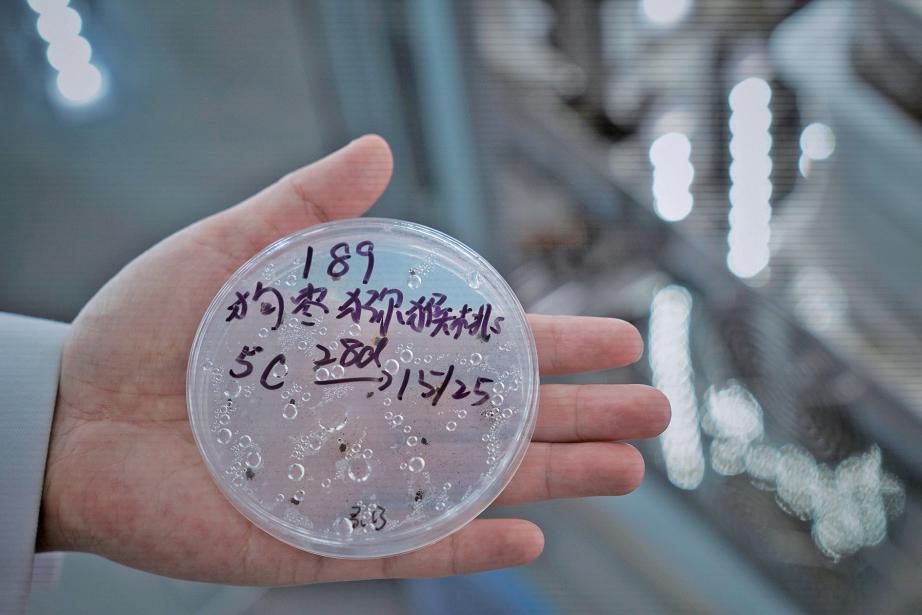

日前,我国容量最大的植物种质资源库——国家植物种质资源库项目主体结构全面封顶。这一被称为植物“诺亚方舟”的项目计划2026年年底运营,届时第一批种子将入库保存。
已经采集到的种子存放在哪里?在国家植物园(北园)西侧,有两排灰色平房,贴着包装间、种子清理室、干燥间、冷库等门签。在这里,从全国收集到的种质资源经过签收登记、清理筛选、X光检测、数量估算、干燥包装等流程后,将被放置在零下20℃的冷库中密封保存。
近日,新京报记者探访了这座被称为“生命冷藏室”的国家植物种质资源库预备库。运营一年来,这里不仅已经保存种质资源近万份,也为建立种质库标准制度、磨合运营机制、锻炼科研团队打下基础。新京报记者 张璐

12月16日,国家植物园,国家植物种质资源库预备库,装着种子的冷库里显示温度为零下21℃。 摄影/新京报记者 薛珺
预备库虽小 五脏俱全
国家植物种质资源库位于国家植物园(北园),建成后将收集来自世界范围内的植物种质资源7万种以上约200万份,实现中国珍稀濒危植物全覆盖。
为确保种质资源库明年底建成后尽快投入运营,国家植物园(北园)整合全园科研力量成立运营专班,开展种质资源收集和保藏两项核心工作。此前,国家植物园(北园)高级工程师孟昕专注研究丁香属植物,如今成为了收集组的负责人。
“虽然预备库只有简单的两排房子,但是‘麻雀虽小、五脏俱全’,这里涵盖了种子从收集、处理到储存的全流程。种子收集回来后,首先来到这间屋子。”她推开预备库的登记室,地上堆放着几个大纸箱,桌上有一摞厚厚的标本,被用报纸或者纸壳一一分隔、压住。
纸箱里,各式各样的种子被分装在不同的袋子中,每袋里的种子数量都大于2500粒。带着丝状柔毛的芦苇种子,像一团羽绒服的毛领子;白杜种子是红色的,大小和花椒粒差不多;有着坚硬褐色外壳的核桃也是种子,同样需要采集至少2500个,并背下山。
孟昕说,千奇百怪的种子需要繁殖和传播,有的种子利用风来传播,比如蒲公英的种子会形成绒毛状的结构,像一把会飞的小伞;有的种子需要随水漂流传播,整体会比较轻;有的则利用人和动物传播,比如苍耳种子上的刺很容易附着在动物的皮毛和人的衣服上;还有的种子会炸裂,通过弹射传播。这些种子都需要采集。
野外采集需要集齐5样东西:一份大于2500粒的种子,满足未来储存和后期做萌发试验的需求;3份植物标本,方便后期分类学专家进行准确的物种鉴定;4-5张当时的生境和带有植物特征的照片;一份用于遗传物质提取并保存的植物DNA材料,通常是3-5片鲜嫩的叶片,可以用于物种分子鉴定或功能研究;一份采集记录表。这些物品通常会被快递回北京,如果是珍贵的植物,则由采集人员“人肉”背回北京。
3类物种的种子需要优先采集,即珍稀濒危、区域特有、有重要应用价值的物种。其中,采集国家重点保护野生植物的种子需要向相关部门申请采集许可。
采集过程快乐也伴随艰险
收集组的7位组员来自国家植物园的各个岗位,这两年,他们的足迹遍布东北、华北、西北等“三北”地区。采集种子是一个非常快乐、解压的工作,可以从植物上摘取,也可以在地上捡拾,但过程中也伴随着艰险。
孟昕说,2000多米、人迹罕至的高山上没有路,走起来格外困难,更何况是背着高枝剪等工具和采集到的种子、标本。“往往眼前是一片云杉林,大家要想办法钻过去。在没有信号的山林中,我们需要在软件上打开轨迹走,再按轨迹走回来,不然根本找不到回来的路。”
丁香叶忍冬生长在门头沟荒无人烟的悬崖峭壁上,科研人员需要冒风险攀爬坡度为45度的陡峭石壁去采集种子。每次跑野外,也未必能收获有效的种子。受到气候变化影响,采集种子的时间变得难以确定。有一次,他们在延庆看到,紫椴结实率挺高,种子也颗颗饱满,但拿回来用X光机检查,却发现其空瘪率非常高。
白天采集到种子,晚上在宾馆也不能闲着。对于部分种子,科研人员需要在采集当晚进行预处理,清理上面粘着的枯枝落叶,并将浆果果肉剥落,取出种子并风干。在炎热的夏季,被压扁的植物标本也需要及时用烘干机进行处理。回忆今年在长白山采集种子的经历,孟昕说,他们每天早上七点多出发,傍晚四五点才能回到宾馆吃口饭,处理种子经常工作到夜里十二点。“连续一周下来,人是很疲劳的。”
采集种质资源,单靠国家植物园的力量是不够的。近两年,他们还会委托地方植物园等兄弟单位、国内科研院校支持采集。目前,预备库已收集新疆、吉林、河北等地种质资源近10000份,涉及163个科、736个属、1783个种/变种,其中包括珍稀濒危物种大花杓兰、山西杓兰、红景天、紫椴等50余种。
这些种子到达预备库第一站“登记室”后,会获得一个新且唯一的身份ID号,这个库编号以NBG开头,它被打印在一张二维码标签纸上,标签上还包含采集号、种名、科名等信息。
入库前种子经历5个步骤
按照国际规范,种质资源从野外采集到入库保存,都需历经签收登记、清理筛选、质量检测、数量估算、干燥包装等标准化流程。
签收登记后,种子会被送往清理室,这里放置着不同孔径的筛网。工作人员需要尝试找到合适网眼的筛子,将种子与杂质分离开来。旁边还有一台种子净度风选仪,将种子放进仪器中,灰尘、碎叶等质量轻的物质会被风吹出管道,较重的种子也会留下来。
在操作台前,簸箕中装满了种子,清理人员用手将干瘪的种子一一挑出,留下粒粒饱满的种子。种子清理机将空气向上吸,使种子中的灰尘、碎屑吸附在滤网上,从而保护工作人员的呼吸系统。
被精心筛选清理过的干净种子,会取出部分计数,再估算出千粒重和种子数量。兰花的种子轻如尘埃,如何计数?在计数室中,超微量天平以克为单位称重,它可以精确到小数点后的7位。
接着,种子会被装进信封或布袋,在相对湿度15%、温度15℃的干燥间脱水,干燥至约5%的含水量。种子含水量每降低1%,其寿命增加一倍。
干燥后的种子将被送往包装间。在这里,它们会做X光检查,确保其种子饱满情况。每份种子会被包装进大大小小的密封瓶罐中,并贴上二维码标签纸。密封罐内,还会放一个小硅胶袋用于检测湿度。一旦容器漏气或者潮湿,硅胶粒会变色,以便工作人员及时发现并更换瓶子或密封圈。
最后,记者跟随孟昕来到零下20℃的冷库,这里的大门贴着“当心冻伤”的黄色提示牌。走进大门,四个制冷机源源不断吹出冷风,尽管裹着厚重的羽绒服,这里的冷气仍然让人忍不住打颤。各种颜色、不同大小的种子装在密封罐中,摆在货架上。在这里,它们的理论保存期限可以超过100年。目前,工作人员取放种子需要经过一番“寒彻骨”,未来国家植物种质资源库的冷库是自动化库,机械臂将代替人进行存放种子的操作。
对种子难题开展攻克研究
绝大部分的种子可以通过低温干燥的方式进行长期保存,但也有少数种子叫“顽拗性种子”,比如板栗和荔枝、桂圆、芒果等热带水果,它们的种子不能通过这种方式保存,需要通过试管苗库或者超低温库的方式进行补充保存。试管苗需要定期继代,是不小的工作量。
所以,明年运营的国家植物种质资源库不仅有零下20℃长期保存库,还将包括零下196℃液氮超低温保存系统、试管苗库、DNA库和活体植物资源圃等多种资源类型保存单元。
国家植物园(北园)副研究员、种子生物学博士李爱花说,中国有2.5万多种种子植物,目前只有部分物种已经明确产生“顽拗性种子”。顽拗性种子的判断,是一个非常关键的科学问题。“顽拗性种子无法脱水干燥,目前我们正开展攻克研究,试图破解顽拗性种子辨别和保存难题。”
收集到的种质资源还需进行定期活力检测,保证科研人员需要它们的时候,处于冷冻状态的它们能够被唤醒,并重新生长。在预备库萌发室,科研人员也在探究不同植物的萌发条件,低温培养箱、光照培养箱可以设置不同的温度和光照时间,为种子萌发试验提供各种条件。“疑难萌发种子休眠解除机理”也是国家植物园正在研究的课题。
明年年底运营的国家植物种质资源库,规划收集来自世界范围内的植物种质资源7万种以上约200万份,涵盖约中国80%高等植物种和世界10%高等植物种的植物种质资源。除了植物种子,种质资源还包括试管苗种质,DNA,植物活植株,花粉和孢子,超低温保存植物组织器官、植物微生物等种质。

12月16日,国家植物园,国家植物种质资源库预备库,一位工作人员用镊子将干瘪的种子一一挑出,留下粒粒饱满的种子。

12月16日,国家植物园,国家植物种质资源库预备库,“种子处理卡”上详细记载着种子到来和清理情况,并贴有二维码标签纸。
追问
为什么要收集种质资源?
收集种质资源有何意义?国家植物园管委会主任、正高级工程师贺然说,种质资源库承载着三重时代使命:作为遗传信息的诺亚方舟,维系着物种基因的多样性宝库;作为生态文明的稳压器,为应对气候变化提供关键性战略储备;作为绿色科技的种质库,持续供给粮食安全、生态修复、清洁能源等领域的创新源泉。
“一个物种可以成为一个国家的重要经济来源,甚至是支柱产业,因此其野生种质资源的价值不可估量。”李爱花举例说,猕猴桃被誉为新西兰“国果”,其品质享誉全球。但许多人不知道的是,猕猴桃母本中华猕猴桃其实原产于中国。上世纪初,它被传教士带回新西兰,经过当地培育,才诞生了众多商业品种。
在基因层面上,种质资源的价值更为关键。她说,一个作物的栽培品种基因纯度越高,其对特定病害的抵抗能力往往越单一,一旦发生病害,便可能面临全军覆没的风险。反之,如果在种子库中保存的野生种质资源里,寻找到携带抗病基因的材料,就有望为整个产业提供生存的转机。“这类野生种可能产量很低、外观不佳、口感也不理想,以当前的标准看似乎没有直接利用价值。”她解释道,“但在未来某一天,当面对前所未有的病害或环境威胁时,它所携带的一个关键基因,或许就能拯救一个品种甚至整个产业。”因此,尽可能全面地保存野生植物种质资源,是一项关乎未来的战略性工作。
从生物多样性的角度看,我国有众多种群规模极小或濒临灭绝的濒危植物,它们也需要植物“诺亚方舟”的守护。目前,世界上仅有两株野生百花山葡萄,均位于北京。“如果这两株植物死亡,这一物种便被宣告灭绝,就像动物界的长江白鲟。”李爱花说,种质资源库如果保留了这些珍稀濒危植物的种质资源,一旦它们野外生存发生危机,库里仍保留它们重生的希望。
孟昕说,自己此前只针对丁香属专类植物做科研,此次通过参与种质资源库的前期准备工作,了解了种子采集入库的全流程,这对于今后保育等工作很有启发。“种质库的建设跟人类的命运息息相关,能参与其中,我觉得非常有意义。”
■简介
国家植物种质资源库位于国家植物园(北园)西侧,总占地面积6万平方米,总建筑面积1.1万平方米。遵循“广泛收集、科学保存、深入研究、永续利用”的方针,建成后的种质资源库将收集来自世界范围内的植物种质资源7万种以上约200万份,实现中国珍稀濒危植物全覆盖。

12月16日,国家植物园,国家植物种质资源库预备库,国家植物园(北园)高级工程师孟昕检查光照培养箱内的种子。

12月16日,国家植物园,国家植物种质资源库预备库,光照培养箱内的狗枣猕猴桃的种子。
日前,我国容量最大的植物种质资源库——国家植物种质资源库项目主体结构全面封顶。这一被称为植物“诺亚方舟”的项目计划2026年年底运营,届时第一批种子将入库保存。
已经采集到的种子存放在哪里?在国家植物园(北园)西侧,有两排灰色平房,贴着包装间、种子清理室、干燥间、冷库等门签。在这里,从全国收集到的种质资源经过签收登记、清理筛选、X光检测、数量估算、干燥包装等流程后,将被放置在零下20℃的冷库中密封保存。
近日,新京报记者探访了这座被称为“生命冷藏室”的国家植物种质资源库预备库。运营一年来,这里不仅已经保存种质资源近万份,也为建立种质库标准制度、磨合运营机制、锻炼科研团队打下基础。新京报记者 张璐

12月16日,国家植物园,国家植物种质资源库预备库,装着种子的冷库里显示温度为零下21℃。 摄影/新京报记者 薛珺
预备库虽小 五脏俱全
国家植物种质资源库位于国家植物园(北园),建成后将收集来自世界范围内的植物种质资源7万种以上约200万份,实现中国珍稀濒危植物全覆盖。
为确保种质资源库明年底建成后尽快投入运营,国家植物园(北园)整合全园科研力量成立运营专班,开展种质资源收集和保藏两项核心工作。此前,国家植物园(北园)高级工程师孟昕专注研究丁香属植物,如今成为了收集组的负责人。
“虽然预备库只有简单的两排房子,但是‘麻雀虽小、五脏俱全’,这里涵盖了种子从收集、处理到储存的全流程。种子收集回来后,首先来到这间屋子。”她推开预备库的登记室,地上堆放着几个大纸箱,桌上有一摞厚厚的标本,被用报纸或者纸壳一一分隔、压住。
纸箱里,各式各样的种子被分装在不同的袋子中,每袋里的种子数量都大于2500粒。带着丝状柔毛的芦苇种子,像一团羽绒服的毛领子;白杜种子是红色的,大小和花椒粒差不多;有着坚硬褐色外壳的核桃也是种子,同样需要采集至少2500个,并背下山。
孟昕说,千奇百怪的种子需要繁殖和传播,有的种子利用风来传播,比如蒲公英的种子会形成绒毛状的结构,像一把会飞的小伞;有的种子需要随水漂流传播,整体会比较轻;有的则利用人和动物传播,比如苍耳种子上的刺很容易附着在动物的皮毛和人的衣服上;还有的种子会炸裂,通过弹射传播。这些种子都需要采集。
野外采集需要集齐5样东西:一份大于2500粒的种子,满足未来储存和后期做萌发试验的需求;3份植物标本,方便后期分类学专家进行准确的物种鉴定;4-5张当时的生境和带有植物特征的照片;一份用于遗传物质提取并保存的植物DNA材料,通常是3-5片鲜嫩的叶片,可以用于物种分子鉴定或功能研究;一份采集记录表。这些物品通常会被快递回北京,如果是珍贵的植物,则由采集人员“人肉”背回北京。
3类物种的种子需要优先采集,即珍稀濒危、区域特有、有重要应用价值的物种。其中,采集国家重点保护野生植物的种子需要向相关部门申请采集许可。
采集过程快乐也伴随艰险
收集组的7位组员来自国家植物园的各个岗位,这两年,他们的足迹遍布东北、华北、西北等“三北”地区。采集种子是一个非常快乐、解压的工作,可以从植物上摘取,也可以在地上捡拾,但过程中也伴随着艰险。
孟昕说,2000多米、人迹罕至的高山上没有路,走起来格外困难,更何况是背着高枝剪等工具和采集到的种子、标本。“往往眼前是一片云杉林,大家要想办法钻过去。在没有信号的山林中,我们需要在软件上打开轨迹走,再按轨迹走回来,不然根本找不到回来的路。”
丁香叶忍冬生长在门头沟荒无人烟的悬崖峭壁上,科研人员需要冒风险攀爬坡度为45度的陡峭石壁去采集种子。每次跑野外,也未必能收获有效的种子。受到气候变化影响,采集种子的时间变得难以确定。有一次,他们在延庆看到,紫椴结实率挺高,种子也颗颗饱满,但拿回来用X光机检查,却发现其空瘪率非常高。
白天采集到种子,晚上在宾馆也不能闲着。对于部分种子,科研人员需要在采集当晚进行预处理,清理上面粘着的枯枝落叶,并将浆果果肉剥落,取出种子并风干。在炎热的夏季,被压扁的植物标本也需要及时用烘干机进行处理。回忆今年在长白山采集种子的经历,孟昕说,他们每天早上七点多出发,傍晚四五点才能回到宾馆吃口饭,处理种子经常工作到夜里十二点。“连续一周下来,人是很疲劳的。”
采集种质资源,单靠国家植物园的力量是不够的。近两年,他们还会委托地方植物园等兄弟单位、国内科研院校支持采集。目前,预备库已收集新疆、吉林、河北等地种质资源近10000份,涉及163个科、736个属、1783个种/变种,其中包括珍稀濒危物种大花杓兰、山西杓兰、红景天、紫椴等50余种。
这些种子到达预备库第一站“登记室”后,会获得一个新且唯一的身份ID号,这个库编号以NBG开头,它被打印在一张二维码标签纸上,标签上还包含采集号、种名、科名等信息。
入库前种子经历5个步骤
按照国际规范,种质资源从野外采集到入库保存,都需历经签收登记、清理筛选、质量检测、数量估算、干燥包装等标准化流程。
签收登记后,种子会被送往清理室,这里放置着不同孔径的筛网。工作人员需要尝试找到合适网眼的筛子,将种子与杂质分离开来。旁边还有一台种子净度风选仪,将种子放进仪器中,灰尘、碎叶等质量轻的物质会被风吹出管道,较重的种子也会留下来。
在操作台前,簸箕中装满了种子,清理人员用手将干瘪的种子一一挑出,留下粒粒饱满的种子。种子清理机将空气向上吸,使种子中的灰尘、碎屑吸附在滤网上,从而保护工作人员的呼吸系统。
被精心筛选清理过的干净种子,会取出部分计数,再估算出千粒重和种子数量。兰花的种子轻如尘埃,如何计数?在计数室中,超微量天平以克为单位称重,它可以精确到小数点后的7位。
接着,种子会被装进信封或布袋,在相对湿度15%、温度15℃的干燥间脱水,干燥至约5%的含水量。种子含水量每降低1%,其寿命增加一倍。
干燥后的种子将被送往包装间。在这里,它们会做X光检查,确保其种子饱满情况。每份种子会被包装进大大小小的密封瓶罐中,并贴上二维码标签纸。密封罐内,还会放一个小硅胶袋用于检测湿度。一旦容器漏气或者潮湿,硅胶粒会变色,以便工作人员及时发现并更换瓶子或密封圈。
最后,记者跟随孟昕来到零下20℃的冷库,这里的大门贴着“当心冻伤”的黄色提示牌。走进大门,四个制冷机源源不断吹出冷风,尽管裹着厚重的羽绒服,这里的冷气仍然让人忍不住打颤。各种颜色、不同大小的种子装在密封罐中,摆在货架上。在这里,它们的理论保存期限可以超过100年。目前,工作人员取放种子需要经过一番“寒彻骨”,未来国家植物种质资源库的冷库是自动化库,机械臂将代替人进行存放种子的操作。
对种子难题开展攻克研究
绝大部分的种子可以通过低温干燥的方式进行长期保存,但也有少数种子叫“顽拗性种子”,比如板栗和荔枝、桂圆、芒果等热带水果,它们的种子不能通过这种方式保存,需要通过试管苗库或者超低温库的方式进行补充保存。试管苗需要定期继代,是不小的工作量。
所以,明年运营的国家植物种质资源库不仅有零下20℃长期保存库,还将包括零下196℃液氮超低温保存系统、试管苗库、DNA库和活体植物资源圃等多种资源类型保存单元。
国家植物园(北园)副研究员、种子生物学博士李爱花说,中国有2.5万多种种子植物,目前只有部分物种已经明确产生“顽拗性种子”。顽拗性种子的判断,是一个非常关键的科学问题。“顽拗性种子无法脱水干燥,目前我们正开展攻克研究,试图破解顽拗性种子辨别和保存难题。”
收集到的种质资源还需进行定期活力检测,保证科研人员需要它们的时候,处于冷冻状态的它们能够被唤醒,并重新生长。在预备库萌发室,科研人员也在探究不同植物的萌发条件,低温培养箱、光照培养箱可以设置不同的温度和光照时间,为种子萌发试验提供各种条件。“疑难萌发种子休眠解除机理”也是国家植物园正在研究的课题。
明年年底运营的国家植物种质资源库,规划收集来自世界范围内的植物种质资源7万种以上约200万份,涵盖约中国80%高等植物种和世界10%高等植物种的植物种质资源。除了植物种子,种质资源还包括试管苗种质,DNA,植物活植株,花粉和孢子,超低温保存植物组织器官、植物微生物等种质。

12月16日,国家植物园,国家植物种质资源库预备库,一位工作人员用镊子将干瘪的种子一一挑出,留下粒粒饱满的种子。

12月16日,国家植物园,国家植物种质资源库预备库,“种子处理卡”上详细记载着种子到来和清理情况,并贴有二维码标签纸。
追问
为什么要收集种质资源?
收集种质资源有何意义?国家植物园管委会主任、正高级工程师贺然说,种质资源库承载着三重时代使命:作为遗传信息的诺亚方舟,维系着物种基因的多样性宝库;作为生态文明的稳压器,为应对气候变化提供关键性战略储备;作为绿色科技的种质库,持续供给粮食安全、生态修复、清洁能源等领域的创新源泉。
“一个物种可以成为一个国家的重要经济来源,甚至是支柱产业,因此其野生种质资源的价值不可估量。”李爱花举例说,猕猴桃被誉为新西兰“国果”,其品质享誉全球。但许多人不知道的是,猕猴桃母本中华猕猴桃其实原产于中国。上世纪初,它被传教士带回新西兰,经过当地培育,才诞生了众多商业品种。
在基因层面上,种质资源的价值更为关键。她说,一个作物的栽培品种基因纯度越高,其对特定病害的抵抗能力往往越单一,一旦发生病害,便可能面临全军覆没的风险。反之,如果在种子库中保存的野生种质资源里,寻找到携带抗病基因的材料,就有望为整个产业提供生存的转机。“这类野生种可能产量很低、外观不佳、口感也不理想,以当前的标准看似乎没有直接利用价值。”她解释道,“但在未来某一天,当面对前所未有的病害或环境威胁时,它所携带的一个关键基因,或许就能拯救一个品种甚至整个产业。”因此,尽可能全面地保存野生植物种质资源,是一项关乎未来的战略性工作。
从生物多样性的角度看,我国有众多种群规模极小或濒临灭绝的濒危植物,它们也需要植物“诺亚方舟”的守护。目前,世界上仅有两株野生百花山葡萄,均位于北京。“如果这两株植物死亡,这一物种便被宣告灭绝,就像动物界的长江白鲟。”李爱花说,种质资源库如果保留了这些珍稀濒危植物的种质资源,一旦它们野外生存发生危机,库里仍保留它们重生的希望。
孟昕说,自己此前只针对丁香属专类植物做科研,此次通过参与种质资源库的前期准备工作,了解了种子采集入库的全流程,这对于今后保育等工作很有启发。“种质库的建设跟人类的命运息息相关,能参与其中,我觉得非常有意义。”
■简介
国家植物种质资源库位于国家植物园(北园)西侧,总占地面积6万平方米,总建筑面积1.1万平方米。遵循“广泛收集、科学保存、深入研究、永续利用”的方针,建成后的种质资源库将收集来自世界范围内的植物种质资源7万种以上约200万份,实现中国珍稀濒危植物全覆盖。

12月16日,国家植物园,国家植物种质资源库预备库,国家植物园(北园)高级工程师孟昕检查光照培养箱内的种子。

12月16日,国家植物园,国家植物种质资源库预备库,光照培养箱内的狗枣猕猴桃的种子。